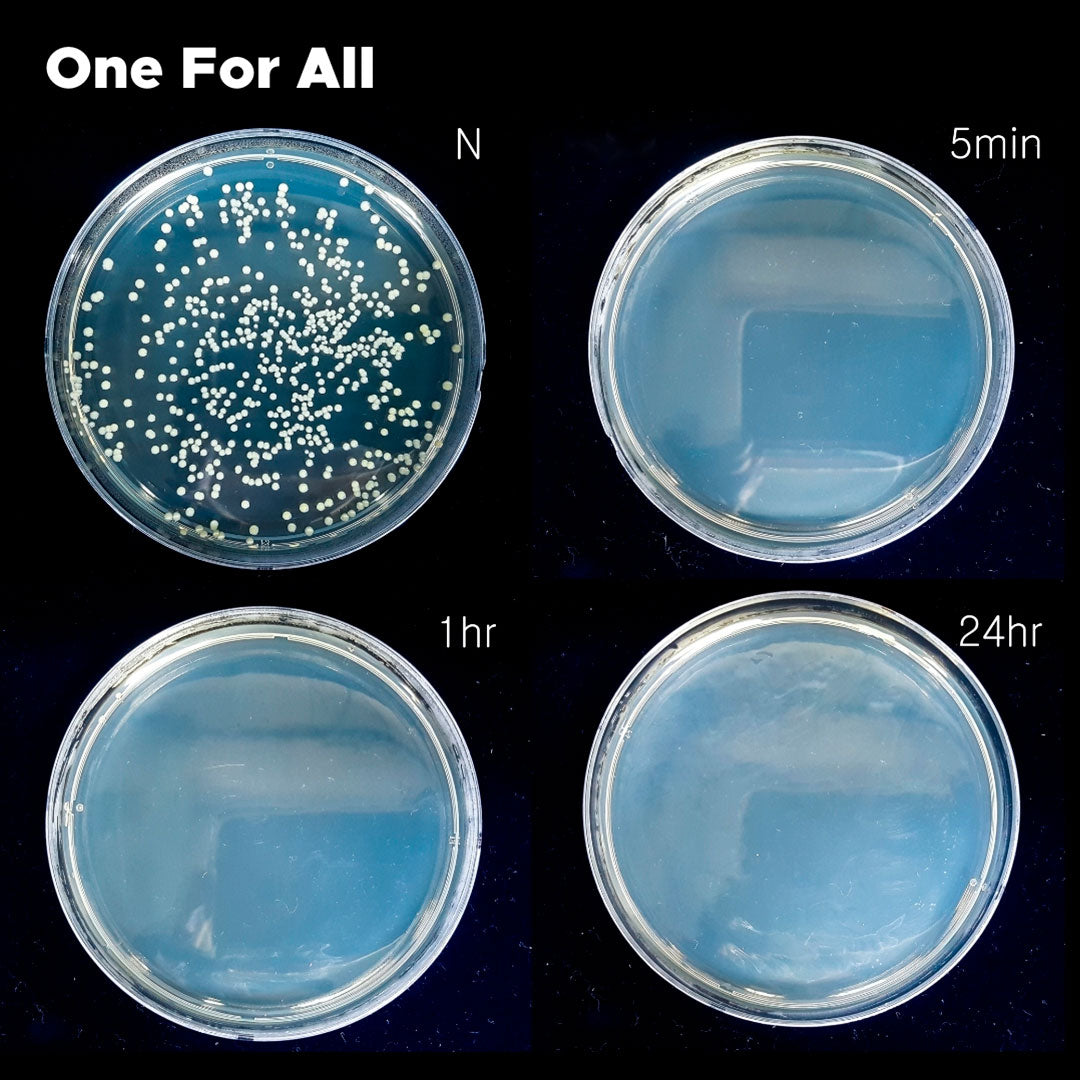

Ho Dental Company
One For All Alcohol-Free Foaming Hand Sanitizer
One For All Alcohol-Free Foaming Hand Sanitizer
Couldn't load pickup availability
[Choice of 500ml or 50ml]
One For All Alcohol-Free Hand Sanitizer is ready to become the go-to hand sanitizer for your medical or dental practice.
It protects better than alcohol hand sanitizers. Our Benzalkonium Chloride (0.13%), Nanodex™-fortified formula goes to work immediately, killing 99.9% of bacteria, viruses, and fungi within 15 seconds. Plus, One For All creates an invisible, non-sticky, protective barrier on the skin that keeps on killing microbes until you wash it off. That’s something that alcohol hand sanitizers can’t do.
What this means for your practice is greater peace of mind. You and your staff are protected when you’re meeting with patients or touching doorknobs, countertops or other commonly-contaminated surfaces.
And because One For All is alcohol-free, our formula is gentle on the skin. That’s especially important in a medical office environment where staff is frequently hand-washing. Alcohol sanitizers and frequent washing can leave skin dry and irritated. Irritated skin creates opportunities for infection. One For All is a water-based formula that features jojoba oil, tea tree, rosemary, and Vitamins C and E for healthy, soft, and moisturized skin.
One For All Alcohol-Free Hand Sanitizer comes in a convenient foaming pump bottle. Just apply 1-2 pumps of sanitizer and rub your hands together until dry.
Demand more from your hand sanitizer. One For All kills germs continuously until your wash it off. And it keeps your hands feeling smooth and moisturized. That makes it worthy of becoming the one sanitizer for your practice.
Also available in a 50 ml travel size.
Share